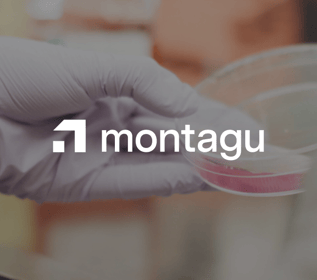

You’re different. Your search partner needs to be, too.
Proprietary technology, curated network access, and world-class service come together to deliver a modern executive search experience.

Today’s companies face challenges that demand a fundamentally different kind of search.
When you can access the entire talent market — active, passive, and hidden candidates alike — your next great hire is no longer a gamble.
We make this possible for our partners in a way unlike any traditional approach.

An exclusive referral network that accesses the total market on your behalf
Our Expert Network of industry leaders, executives, and high performers personally introduces us to top talent, expanding our reach and yielding a pipeline competitors can’t match.
Together, they underpin our comprehensive service and expertise to deliver breadth, speed, and precision to each search — so we can help you find the right people faster, without compromise.

Your search partner is the most important hire you’ll make.
Hunt Club's offering includes both executive hiring and strategic team build-outs.
We don’t just know great talent. Great talent knows us.
We work with early-stage, growth-stage, and enterprise businesses across a broad range of industries and functions.
Providing a consultative service focused on solving our clients' leadership challenges and gaps, we help hire leaders and build out teams as you scale, shift, or stabilize.
High-fit talent to help you drive outcomes, and returns.
Find proven leaders without the risk.
Grow from 0 to 1 or 1 to 100 with the right talent.
Strategic talent for companies scaling toward — or beyond — IPO.
-
High-fit talent to help you drive outcomes, and returns.
-
Find proven leaders without the risk.
-
Grow from 0 to 1 or 1 to 100 with the right talent.
-
Strategic talent for companies scaling toward — or beyond — IPO.
Insights & Intel To Drive Your Search Strategies
The latest insights and trends in executive search.